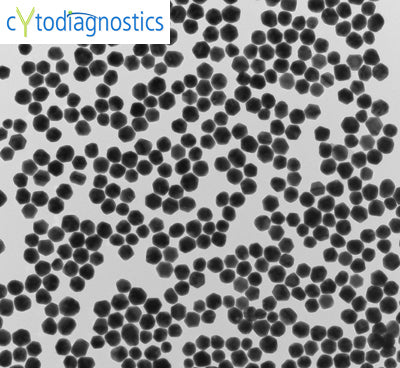
60nm gold nanoparticles TEM

Composition: Citrate stabilized gold colloid
Core Size: 60nm
Absorption max: 544nm
Particles per ml: 1.96E+10
Purity: >99% reactant free
Formulation: Supplied in 0.1mM phosphate buffered saline (PBS)
Intended use: Our extensively purified reactant free gold nanoparticles are ideal for sensitive applications requiring a minimum amount of contaminating reactants remnant from the manufacturing process. This product is well suited for conjugate development by passive adsorption of proteins and other ligands to the gold nanoparticle surface. The resulting conjugate can be used in blotting, electron microscopy and immunohistochemistry applications.
Properties
Cytodiagnostics reactant free gold nanoparticles are made using a unique proprietary protocol resulting in pure, reactant free particles with superior size distribution and shape compared to that of the leading competitor.
Our gold nanoparticle preparations have a narrow size distribution (CV of less than 15%), exceptional protein adsorption properties and more than 95% spherical particles. In addition, low batch to batch variability (+/- 2nm) assures you as a customer always end up with a product within the specified size range ordered.
All of our batches go through stringent quality control prior to shipment to our customers using dynamic light scattering to guarantee size and monodispersity and lot specifications are supplied with each product.
Storage
Store product away from direct sunlight at 4-25°C. Lower temperature prolongs the shelf life of the product.
Do NOT freeze. Freezing causes irreversible aggregation of the gold nanoparticles.
When stored as specified the product is stable for at least six months.
Download: Gold Nanoparticle Product Brochure